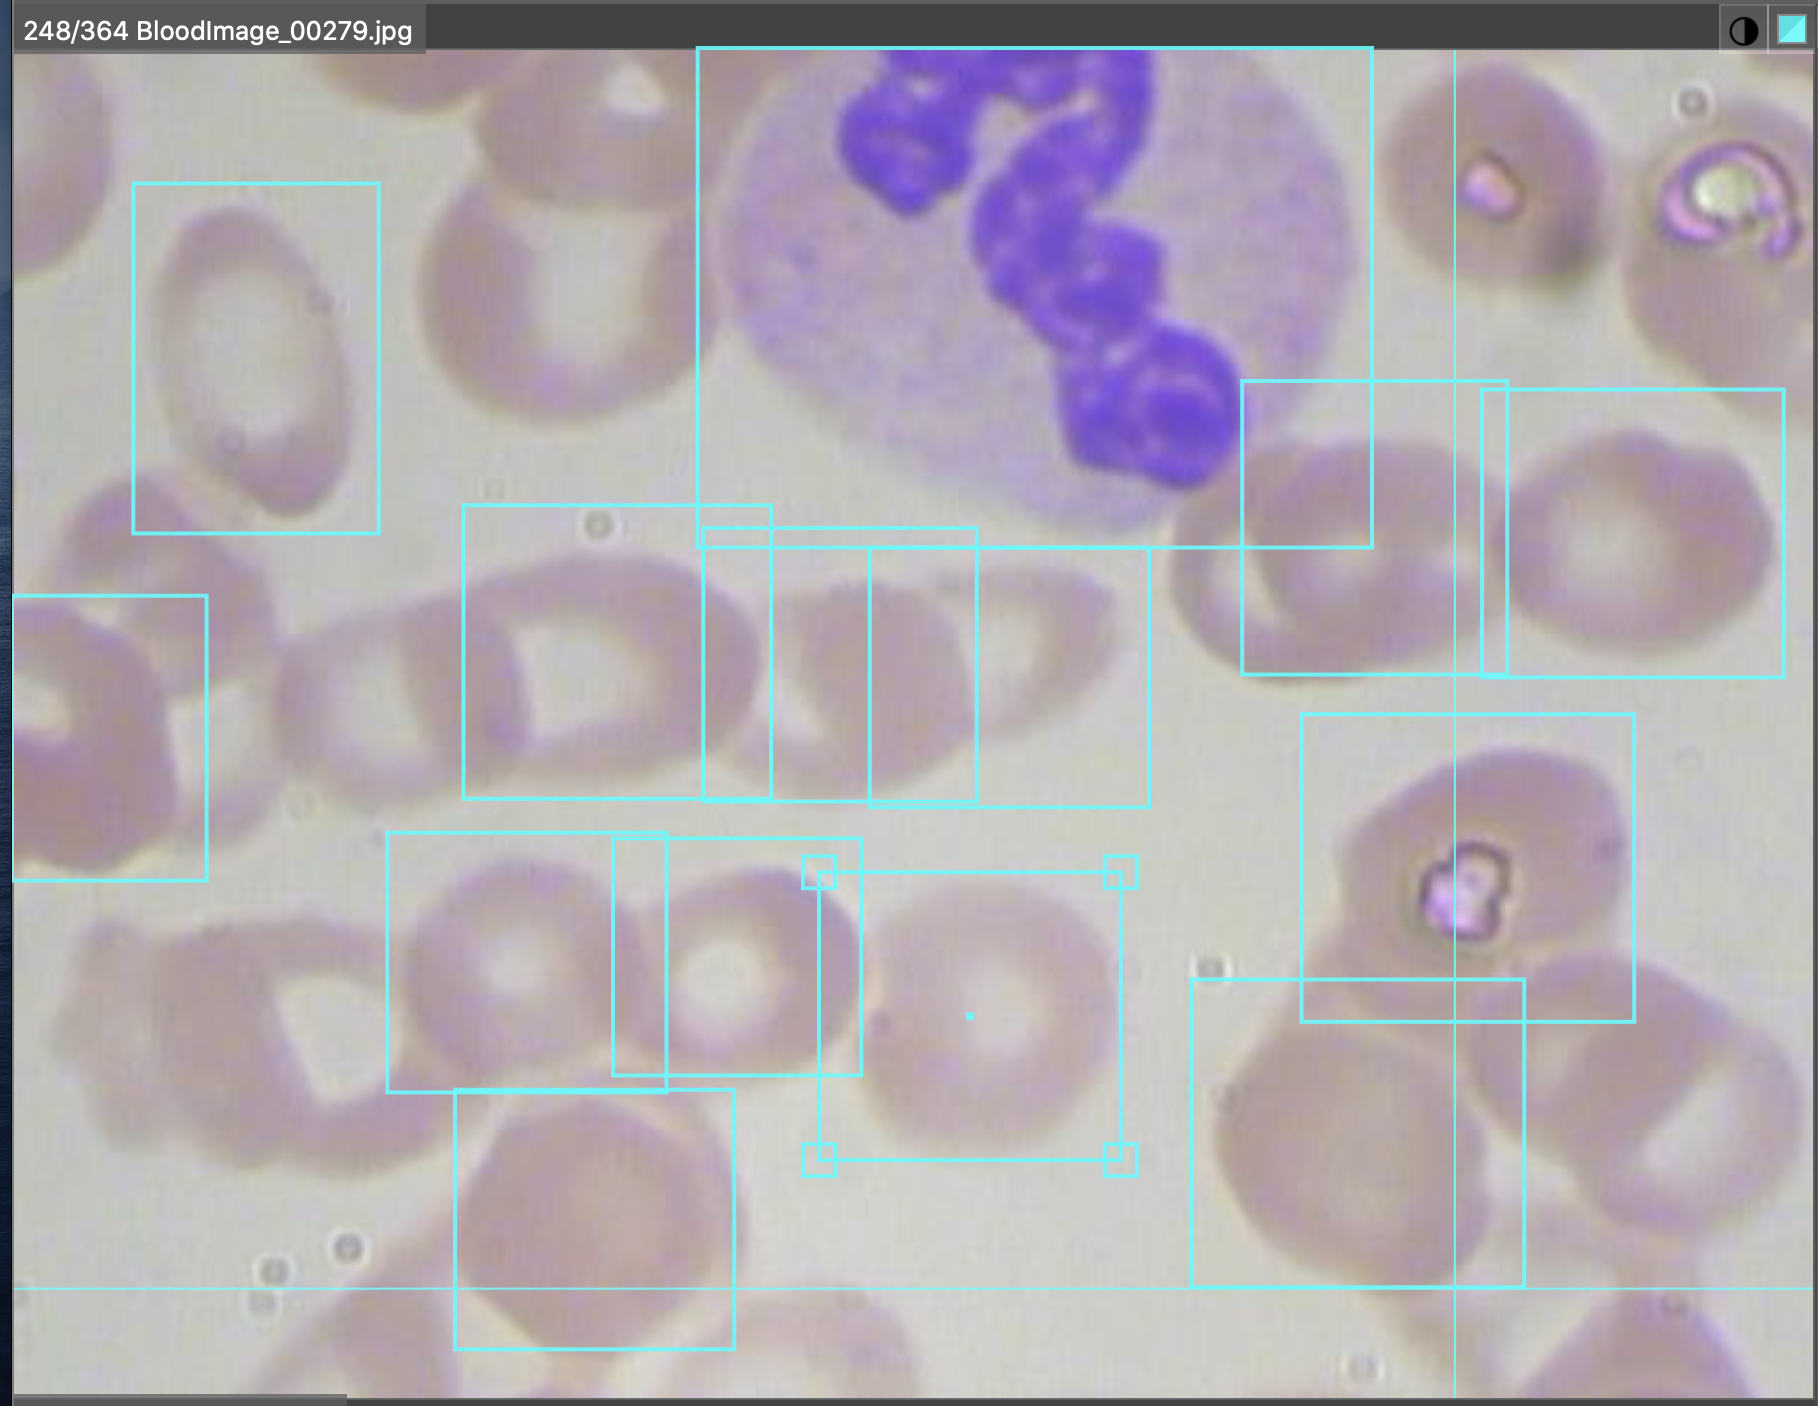
Microscope slide showing annotated blood cells.
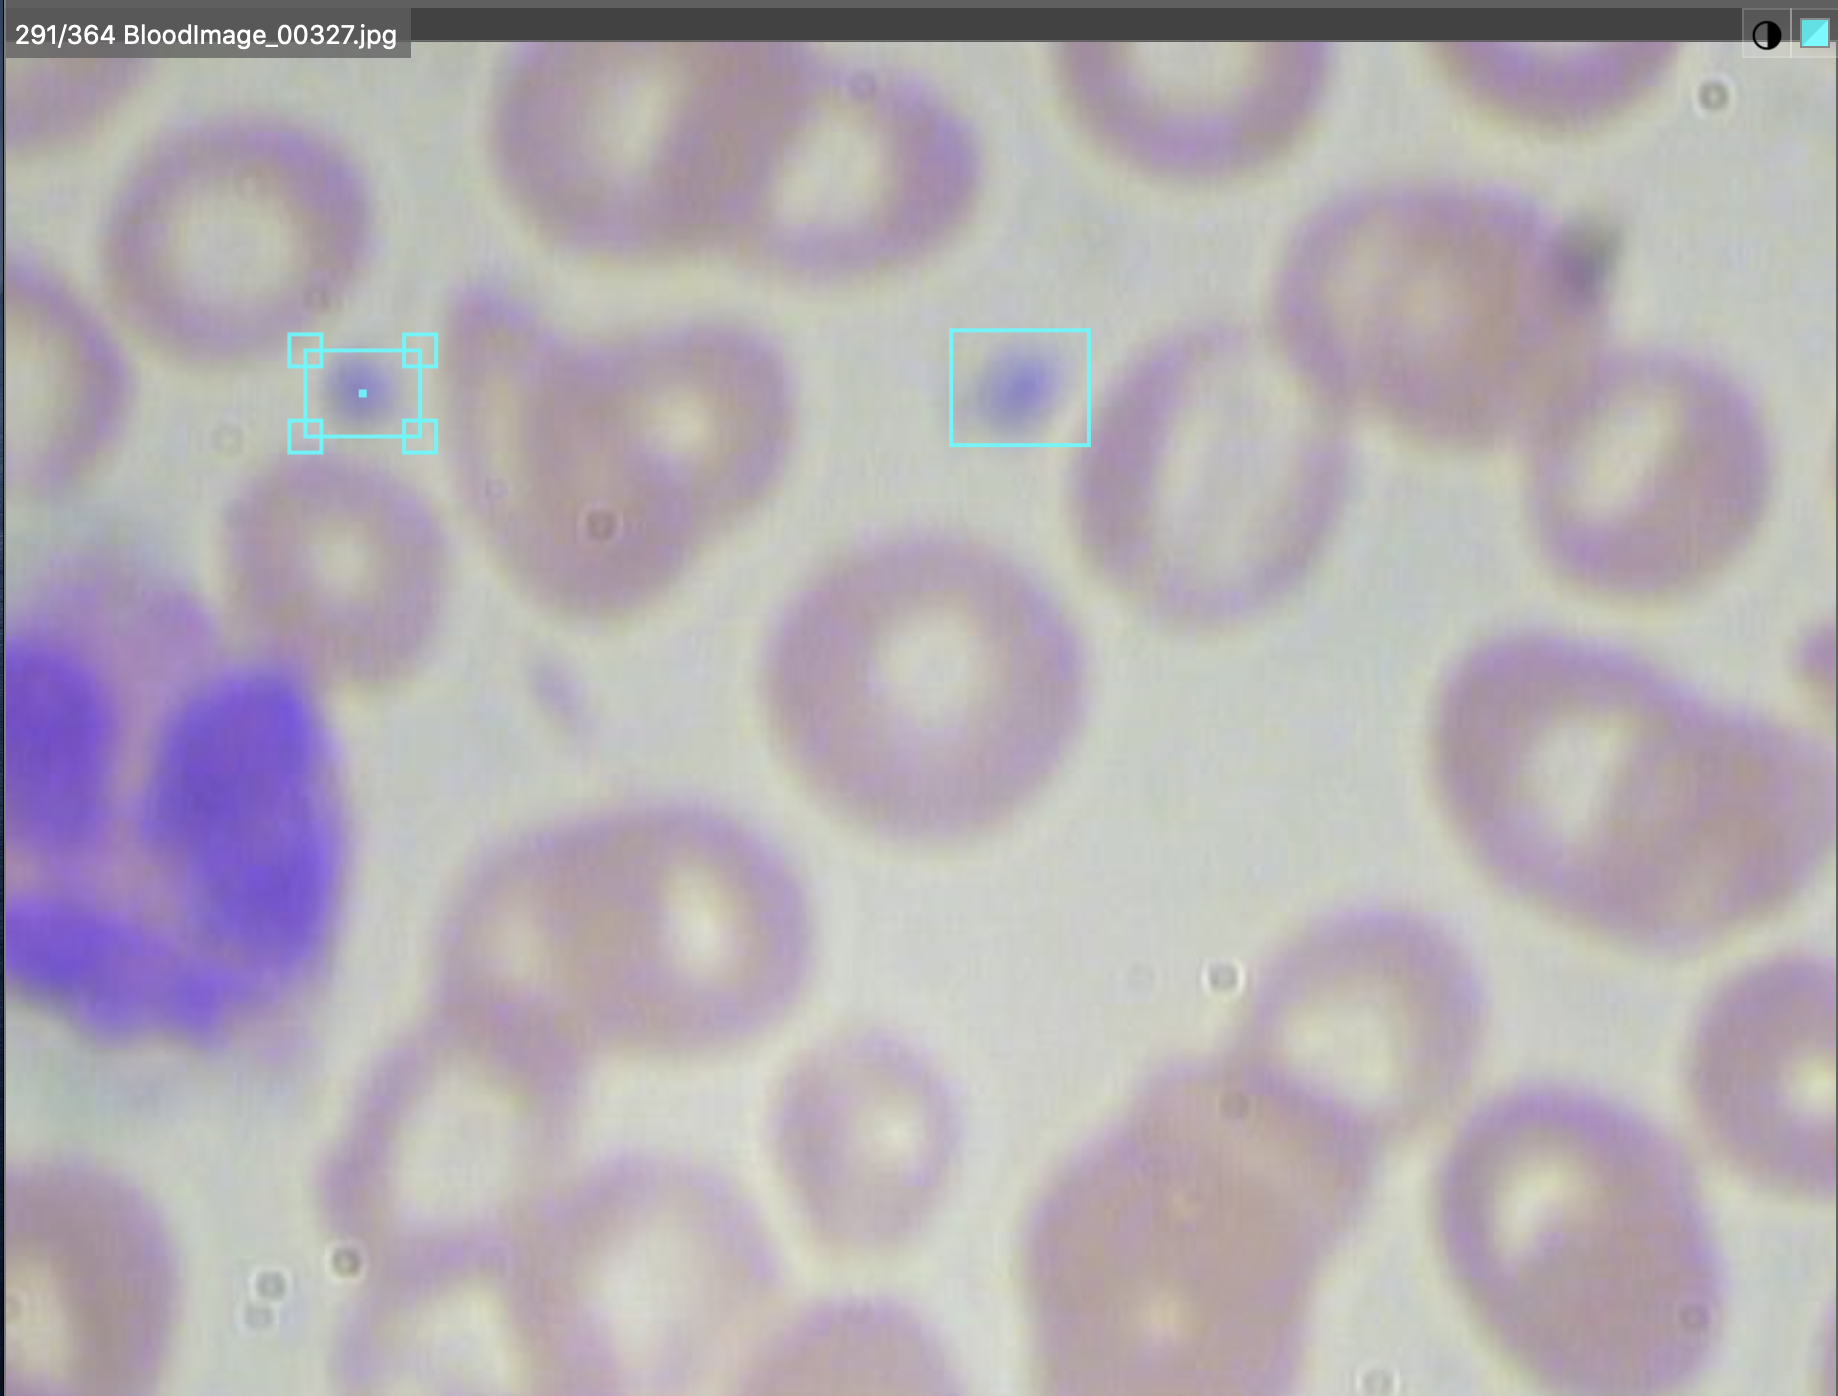
Microscope slide showing annotated platelets.

The Blood Count and Cell Detection (BCCD) dataset, a widely used object detection benchmark with 364 microscope images across three classes (WBC, RBC, and Platelets), had significant annotation gaps in its original release. The Roboflow team reviewed each image and added 187 missing labels, 183 of them red blood cells, plus three white blood cells and one platelet, and re-released the corrected dataset publicly. The improved version gives teams a more complete foundation for training or evaluating medical imaging models without needing to re-audit the raw annotations themselves.
Computer vision is revolutionizing medical diagnoses by assisting doctors with patterns they may not have seen or identifying an error they may have overlooked.
Thus, it's unsurprising one of the more popular "hello world" datasets of object detection is the blood count and cell detection dataset (BCCD). Now two years old, this is a dataset of blood cells photos, originally open sourced by cosmicad and akshaylambda. There are 364 images across three classes: WBC (white blood cells), RBC (red blood cells), and Platelets.
Upon examining this dataset, however, the Roboflow team discovered there is room for improved labelling.
Here's an original image and raw labels that appears to be comprehensive:
Yet here's another original image and its raw labels that is clearly missing bounding boxes:
Now, fair warning, the Roboflow team are not doctors or domain experts and do not claim to have cell biology expertise. However, in reviewing the original 364 microscope image examples, there were examples like the one above where labels can be intuitively added.
Upon reviewing and relabeling, the Roboflow team added 187 labels: 183 RBC, three WBC, and one Platelets. That dataset is freely available here.
(If you're looking to build an object detection model leveraging this dataset, be sure to check our computer vision tutorials)
We'll be running tests on the importance of missing labels shortly. Stay tuned!
Cite this Post
Use the following entry to cite this post in your research:
Joseph Nelson. (Feb 14, 2020). Releasing an Improved Blood Count and Cell Detection (BCCD) Dataset. Roboflow Blog: https://blog.roboflow.com/releasing-an-improved-blood-count-and-cell-detection-dataset/